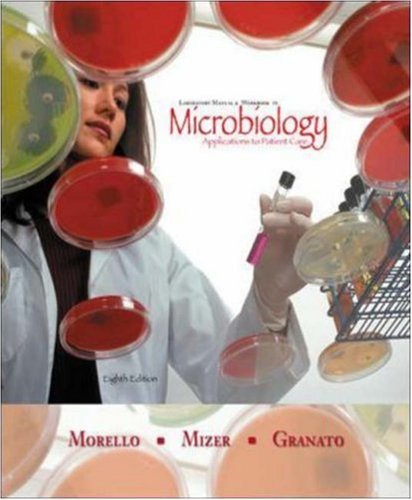
Product Image

Your cart is empty.
Shop Now(407) 622-6657
Shipping is just $4.99
(407) 622-6657
Shipping is just $4.99
Author Josephine Morello
Format Spiral-bound
Publisher McGraw-Hill Science/Engineering/Math
We can notify you when we add a copy of this item to our inventory using your account.
No copies of this item are currently available.